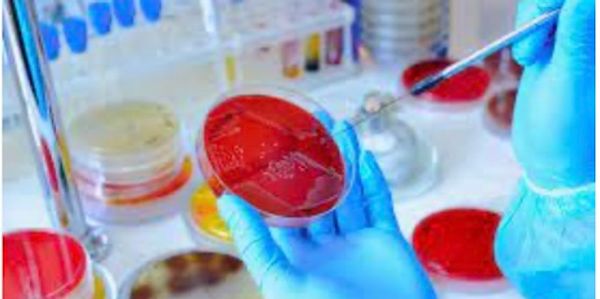

Qualitative and quantitative assessments of non-sterile raw materials and finished products using USP, FDA and in-house methods.

Microbial and sterility testing services supporting cosmetics & OTC, nutraceutical & dietary Supplements, medical devices and pharmaceuticals
We use cookies to analyze website traffic and optimize your website experience. By accepting our use of cookies, your data will be aggregated with all other user data.